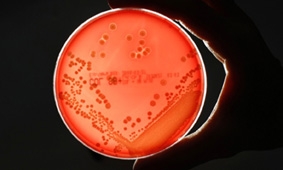
Phát hiện điểm yếu của “siêu vi khuẩn” kháng thuốc

Nhằm đảm bảo nhu cầu điều trị và dự trữ máu cho cấp cứu, điều trị bệnh trong những ngày đầu năm 2026, Sở Y tế TP Cần Thơ phát động “Tuần lễ hiến máu tình nguyện ngành Y tế Cần Thơ”.
-
Tại sao chúng ta không có ký ức trẻ thơ ?

-
Kỹ thuật “siêu làm mát” tăng thời gian bảo quản nội tạng cấy ghép

-
Thử nghiệm thành công vắc-xin chống u não trên chuột
-
Những cách giúp bạn đưa ra quyết định tốt hơn

Khi ở giữa những sự chọn lựa, chúng ta khó mà đưa ra một quyết định sáng suốt, nên thường phải mất rất nhiều thời gian cân nhắc. Qua nhiều nghiên cứu, các nhà khoa học đã tìm ra những cách có thể giúp bạn đưa ra quyết định chính xác, dựa trên lý trí chứ không phải theo cảm xúc.
-
5 ứng dụng có thể thay đổi cuộc sống từ “siêu vật liệu” graphene

Cấu trúc phân tử dạng tổ ong của graphene (trái) và một mẩu vật liệu mỏng, nhẹ và siêu bền làm từ “siêu vật liệu” này. Ảnh: azonano/NBC News1. Pin
-
An toàn và tiết kiệm điện với “đầu sạc điện thoại thông minh”

-
Hey Joe - ly pha cà phê “thông minh”

-
Pin hữu cơ mới rẻ tiền và thân thiện với môi trường

-
Bụng không khỏe - dấu hiệu ban đầu của các bệnh ở não

1. Chỉ dùng kháng sinh khi cần thiết
-
Triển vọng chế tạo thuốc “trẻ mãi không già”

-
Phát hiện điểm yếu của “siêu vi khuẩn” kháng thuốc
-
Tìm ra mối liên hệ giữa stress và đau tim

-
Hiến máu mang đến lợi ích cho cộng đồng và cá nhân

- Review đai lưng bảo vệ cột sống của thương hiệu Haruco
- Điểm sáng ứng dụng công nghệ hiện đại trong chẩn đoán hình ảnh và xét nghiệm của y tế Cần Thơ
- Tất cả các cơ sở y tế đều tư vấn, xét nghiệm HIV, viêm gan B và giang mai cho phụ nữ mang thai
- Sở Y tế TP Cần Thơ thẩm định cấp phép hoạt động cho Phòng khám Đa khoa Hòa Hảo - Long Mỹ
- Buồng trứng đa nang có tự khỏi được không? Hiểu đúng sẽ giúp bạn vượt qua hội chứng này
- Chia sẻ kinh nghiệm dự phòng lây truyền HIV, giang mai và viêm gan B từ mẹ sang con
- Mổ 2 giai đoạn điều trị bệnh rò đại tràng sigma - bàng quang phức tạp
- Đẩy mạnh dự phòng HIV, giang mai và viêm gan B ở trạm y tế
- Cảnh báo về loại ma túy cực độc fentanyl, độc tính cao gấp 50 lần so với heroine
-
Các bệnh viện ở Cần Thơ diễn tập báo động đỏ ngoại viện

- Báo động xu hướng gia tăng ca bệnh sốt xuất huyết nặng tại ĐBSCL
- Tiếp nối hành trình trong chuỗi Chăm sóc sức khỏe cộng đồng của Bệnh viện Quốc tế Phương Châu Sóc Trăng
- Cập nhật những tiến bộ mới trong phẫu thuật và can thiệp cấp cứu bệnh lý động mạch chủ
- Cảnh báo về loại ma túy cực độc fentanyl, độc tính cao gấp 50 lần so với heroine
- 6 nhiệm vụ trọng tâm nâng cao chất lượng chăm sóc sức khỏe nhân dân Cần Thơ theo Nghị quyết 72/NQ-TW
- Mổ 2 giai đoạn điều trị bệnh rò đại tràng sigma - bàng quang phức tạp
- Sở Y tế TP Cần Thơ thẩm định cấp phép hoạt động cho Phòng khám Đa khoa Hòa Hảo - Long Mỹ
- Fucoidan Care - Giải pháp chăm sóc sức khỏe từ Fucoidan tinh khiết Nhật Bản
- Chia sẻ kinh nghiệm dự phòng lây truyền HIV, giang mai và viêm gan B từ mẹ sang con













































